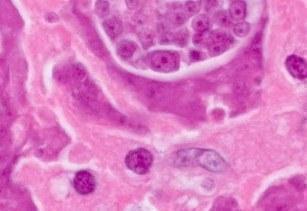
Descubrimiento cáncer producido por células de un parásito

Nace la Universidad
Los fundadores
Primer Rector y primera sede
Terrenos para el futuro
Aparece el colegio
Se crea la Facultad de Química
Se escribe el himno de la Universidad
Inicia construcción de ciudad universitaria Laureles
Fallece el primer rector, Mons. Manuel José Sierra
Creación Facultad Arquitectura y Urbanismo
La Universidad recibe Sello Pontificio
Aprobación estatutos y creación emisora
Traslado a Avenida La Playa
Adquisición terrenos sector Robledo
Se crea el CIDI
Elección rector Mons. Luis Alfonso Londoño Bernal
Apertura programas en Marinilla
Inicio programas de etnoeducación
Elección rector Mons. Eugenio Restrepo
San Juan Pablo II llega a Medellín
La UPB llega a Laureles
Nace la idea de la UPB en Bucaramanga
Inicios de la Seccional Bucaramanga
Nuevos terrenos para la Seccional Bucaramanga
UPB Montería es oficial
Se inaugura la CUB
Biblioteca Central en Medellín
Primeros programas en Montería
Primeros graduados en Montería
Surge la Seccional Palmira
El MEN autoriza la creación de la Seccional Palmira
Nuevo Rector en Medellín
Crece campus en Bucaramanga
Sede principal en Montería
Nuevos terrenos en Bucaramanga
Seccional Montería crea Laboratorio de Calidad de Aguas
Primeros programas en Palmira
Inicia operaciones Frecuencia Bolivariana
Elección rector Mons. Luis Fernando Rodríguez Velásquez
Acreditación en Alta Calidad
Nuevo espacio para el deporte
Plan Maestro para Bucaramanga
Acreditación Laboratorio de Calidad de Aguas
Acreditación se renueva
Septuagésimo quinto aniversario
Se inaugura el nuevo Edificio de Formación Avanzada
Nuevo Rector General
Más espacios en Medellín
Nuevos estatutos para la universidad
Montería inaugura nuevos espacios
Surgen los focos estratégicos
Nace la MicroRed
Montería inaugura nuevos espacios
Modernos laboratorios en Bucaramanga
Laboratorio de Energías Renovables en Montería
Nueva construcción en Bucaramanga
Descubrimiento científico de impacto
Nuevo espacio para el deporte en Montería
Conmemoración del octogésimo aniversario de la universidad
Certificación del Centro de Conciliación en Montería
Inauguración de nuevos espacios en Montería
Acreditación Institucional Multicampus
Nuevo edificio en Montería
Certificación Carbono Neutro
Investigación de mayor impacto en el año
Categoría plata Basura Cero
Se adquiere microscopio de alta sensibilidad, único en Colombia
Categoría oro en Basura Cero
Se realiza procedimiento EXIT, el primero en Latinoamérica
Diego Marulanda, nuevo Rector General
UPB, primera en contribución al ODS 7
Nueva patente entre la UPB y el Metro de Medellín
Expresidente de la Corte Suprema, decano de la Escuela de Derecho y Ciencias Políticas

El 15 de septiembre Monseñor Tiberio de J. Salazar y Herrera, arzobispo de Medellín, expidió el decreto que declara la fundación de la Universidad Católica Bolivariana.
La primera Facultad que tuvo la Universidad fue la de Derecho, que inició su vida académica con un grupo de profesores y estudiantes que provenían de la Universidad de Antioquia.

El grupo de estudiantes fundadores decidió dedicar la nueva Universidad a la memoria del Libertador de América: Simón Bolívar. La iniciativa fue aceptada por los profesores y por la autoridad eclesiástica. Esta denominación, que tiene un trasfondo educativo, político, social y religioso, marcó la ruta, esencia y devenir de la Universidad: el espíritu bolivariano.

Su primer rector fue Monseñor Manuel José Sierra. La primera sede fue el Edificio Bolívar o Pasaje Bolívar en el sector de Guayaquil. Esta edificación tenía un carácter diverso y albergaba actividades relacionadas principalmente con los negocios. Don Alejandro Ángel, propietario del edificio, cedió, a título gratuito, tres locales en el segundo piso para que los estudiantes recibieran allí sus clases, mientras la Universidad se establecía.

La Universidad adquirió 460.000 m2 de la Hacienda Palestina, para que se constuyera allí el Campus de la UPB en el barrio Laureles. Este hecho fue relevante no solo para la Universidad, sino también para el desarrollo urbano de Medellín, que ya venía en proceso de expasión
En ese mismo año también el Gobierno Nacional de Colombia le reconoce la personería jurídica.

Se crea el Colegio. Su primera sede fue en la calle Juanambú, ocupada por la sección primaria hasta 1961.

Se crea la Facultad de Química Industrial, hoy Ingeniería Química, primera de este género en Colombia. En este año, la Universidad obtiene la aprobación oficial de sus estatutos.

El estudiante de Derecho, Baltasar Uribe Isaza, escribe el himno de la Universidad, con música de Jorge Lalinde.

Inician los trabajos de construcción de la ciudad universitaria de Laureles y se inaugura la Avenida Bolivariana.

Fallece el primer rector de la Universidad, Monseñor Manuel José Sierra, y como su sucesor es nombrado el Pbro. Doctor Félix Henao Botero.

Se crea la Facultad de Arquitectura y Urbanismo (segunda en el país y primera privada). Se anexa a la Universidad la Facultad de Arte y Decorado, creada un año antes por las religiosas del Sagrado Corazón.

En agosto, la Universidad Católica Bolivariana recibe el Sello Pontificio por parte de la Santa Sede. S.E.R Mons. Joseph Beltrami, Nuncio apostólico, lee el decreto de SS Pío XII, en la Catedral Metropolitana. A partir de ese momento, la Universidad cambia su denominación original por la actual: Universidad Pontificia Bolivariana.

La Santa Sede aprueba canónicamente los estatutos de la Universidad. En ese mismo año sale al aire la emisora Radio Bolivariana. El estudiante de Ingeniería Química, Raúl Aguilar, opera los equipos.

La UPB se traslada de la sede del antiguo seminario y se instala en una edificación en la Avenida La Playa con la carrera Girardot.

Se adquieren los terrenos del sector de Robledo, frente al Hospital Pablo Tobón Uribe donde actualmente están las instalaciones de la Escuela de Ciencias de la Salud y la Clínica Universitaria Bolivariana.

Se crea el CIDI, hoy Centro de investigación para el Desarrollo y la Innovación.

Es elegido como rector Mons. Luis Alfonso Londoño Bernal.

Se abren los programas en Marinilla, proyecto pionero de descentralización académica, a cargo del Rector Mons. Luis Alfonso Londoño Bernal.

Inician los programas de etnoeducación en convenio con el Instituto Misionero de Antropología.

Mons. Eugenio Restrepo Uribe es elegido rector de la Universidad. En la ceremonia de posesión le acompañaron el Gran Canciller y el entonces gobernador de Antioquia, Dr. Rodrigo Uribe Echavarría.

San Juan Pablo II llega a Medellín con motivo de su visita a Colombia. La UPB participa en el encuentro con universitarios.

Monseñor Darío Múnera Vélez es elegido como rector.
En ese años comienza el traslado de las dependencias de la sede del Centro al Campus Laureles.

Se empieza a gestionar la idea de crear una universidad católica en Bucaramanga como producto de reflexiones orientadas por Mons. Isaías Duarte Cansino y la participación de Luis Enrique Aramburo Bolaños y Hernán Porras. Luis Alfonso Díaz Nieto, Jorge Enrique Viccini Ramírez, Luis Enrique Aramburo Bolaño, Álvaro García Pinzón y Sergio Gamboa Sepúlveda se dirigen a Mons. Darío Múnera Vélez con el fin de expresarle el deseo de la creación de una seccional de la UPB en Bucaramanga. El 6 de septiembre Mons. Múnera da respuesta positiva a dicha propuesta.

Según acuerdo N°083 del 12 de julio de 1990, el ICFES autoriza el funcionamiento de la Seccional, pero es en 1991 cuando comienzo sus labores académicas con el programa de Ingeniería Electrónica.
En sus inicios, la Universidad Pontificia Bolivariana Seccional Bucaramanga se ubicó en parte de los predios del Seminario Menor San Pio X, entregados en comodato por la Arquidiócesis de Bucaramanga.

La Seccional Bucaramanga adquiere su primer terreno destinado a la construcción de la sede propia, en una extensión de 67.124 m2.
Ese año inician los programas de Ingeniería Industrial e Ingeniería Civil con 77 y 59 estudiantes matriculados, respectivamente.

El Ministerio de Educación Nacional, por Resolución número 4800 del 20 de octubre de 1995, aprueba oficialmente la Seccional de la UPB Montería.

A finales del 95 es inaugurada la Clínica Universitaria Bolivariana.

Se inaugura la Biblioteca Central Mons. Darío Múnera Vélez en Medellín.

El 15 de enero de 1996 se institucionalizan las carreras universitarias de Ingeniería Civil, Ingeniería Agroindustrial y Psicología en la Seccional Montería.

Al finalizar 1996, la UPB Montería expide el título de Especialistas en Derecho Procesal con énfasis en Procedimiento Civil a 29 estudiantes, primeros egresados de la Seccional.

Fundamentado en los principios católicos y en el nivel académico de la Universidad Pontificia Bolivariana de Medellín, el Obispo de la Diócesis de Palmira, Monseñor Mario Escobar Serna, solicita a Monseñor Darío Múnera Vélez crear la Seccional en el municipio de Palmira, Valle del Cauca.

Mediante el Acuerdo del Consejo Directivo CD-01 del 3 de febrero de 1997 y la Resolución No. 2585 de octubre 4 de 2000 del Ministerio de Educación Nacional, se autorizó a la Universidad Pontifica Bolivariana, la creación de una Seccional en Palmira, Valle del Cauca.

En la Sede Central Medellín, el Pbro. Gonzalo Restrepo Restrepo, es nombrado Rector y toma juramento ante el Gran Canciller, Mons. Alberto Giraldo Jaramillo, Arzobispo de Medellín.

Con la entrega de 7.346m2 de construcción, es puesta al servicio de la comunidad la primera etapa de la UPB Bucaramanga con cuatro edificios: los bloques A, B, C Y D.

Se adquieren las instalaciones del Colegio La Presentación como sede principal de la Seccional Montería y comienzan los trabajos de reformas y ampliación.

La Seccional Bucaramanga adquiere un terreno adjunto al de la nueva sede en extensión de 49.990 m2, para un total de 117.114 m2.

La Seccional Montería crea el Laboratorio de Calidad de Aguas especializado en el análisis de la calidad físico-química de este líquido. El laboratorio surge de la necesidad que presenta la región para monitorear la calidad de las aguas del embalse Urrá I y del río Sinú.

La Universidad Pontificia Bolivariana Seccional Palmira inicia su vida académica con el programa de Psicología, en el primer semestre, y Publicidad, en el segundo.

Inicia operaciones Frecuencia Bolivariana, emisora institucional de la Seccional Montería, en los 1160 AM con cobertura en el departamento de Córdoba.

En la Sede Central Medellín, Monseñor Luis Fernando Rodríguez Velásquez es nombrado Rector de la Universidad.

En su aniversario número 70, la Universidad obtiene la Acreditación Institucional de Alta Calidad por parte del Ministerio de Educación Nacional. La ministra de Educación, Cecilia María Vélez White, entregó la Resolución No. 3596.

Se inaugura el Polideportivo Eugenio Restrepo Uribe en Medellín.

Se da inicio a la cuarta etapa del Plan Maestro en la Seccional Bucaramanga y con ella se da apertura al edificio J.

El Laboratorio de Calidad de Aguas de la Seccional Montería recibe una acreditación del Instituto de Hidrología, Meteorología y Estudios Ambientales IDEAM para producir información cuantitativa, física y química, para los estudios o análisis ambientales requeridos por las autoridades ambientales competentes, bajo los lineamientos de la norma NTC-ISO 17025.

Se renueva la Acreditación Institucional de Alta Calidad por parte del Ministerio de Educación Nacional (Resolución N. 10246 de noviembre 22 de 2010).

La Universidad celebra su septuagésimo quinto aniversario. Con la Expo 75 años, la UPB sale a las calles para tomarse varios espacios públicos de Medellín.

La Sede Central Medellín inaugura el nuevo Edificio de Formación Avanzada - Postgrados Mons. Luis fernando Rodríguez Velásquez

El Pbro. Julio Jairo Ceballos Sepúlveda es nombrado nuevo Rector General de la Universidad.

Se inauguran las canchas y el Edificio de Parqueaderos Fundadores del Campus Laureles en Medellín.

Se aprueban unos nuevos estatutos para la Universidad.

En la Seccional Montería se construye en un área de 1.550 m2 el “Cubo” y la zona Deck; un espacio con las condiciones físicas necesarias para ofrecer una zona de descanso y estancia para los estudiantes. Se invierte en la modernización de la biblioteca, cafetería, salas de informática y se inaugura el gimnasio.

Se define la política del macroproceso de investigación, transferencia e innovación con campo de acción para la Sede Central y sus Seccionales y en ella, los focos estratégicos para desarrollarla: Humanización y Cultura; Agua, Alimentación y Territorio; Energía; Salud; Tecnología de la Información y la Comuncación.

UPB presenta la primera MicroRed Inteligente de su naturaleza en Colombia. El Campus Laureles se convierte en un laboratorio de energías renovables.

En la Seccional Montería se construye en un área de 1.550 m2 el “Cubo” y la zona Deck; un espacio con las condiciones físicas necesarias para ofrecer una zona de descanso y estancia para los estudiantes. Se invierte en la modernización de la biblioteca, cafetería, salas de informática y se inaugura el gimnasio.

El Laboratorio de Vibraciones de la UPB Bucaramanga recibe la Acreditación de Calidad ISO17025 otorgado por el Organismo Nacional de Acreditación en Colombia - ONAC, y se convierte en el primero y único certificado en Colombia. Esta Seccional también crea un moderno laboratorio para el estudio de nanomateriales, el cual cuenta con un microscopio FE Schottky de alta resolución, inversión que asciende a los 800 millones de pesos.

Se desarrolla el diseño y la construcción del Laboratorio de Energías Renovables en Montería, en una área de 142 m2. Es un espacio dotado con equipos de generación de energías alternativas, procesado y almacenamiento de biomasa y oficinas para investigadores donde se realiza el monitoreo de los procesos, análisis y resultados de pruebas.

Con la construcción del edificio L, la Seccional Bucaramanga inicia la sexta y última etapa del primer Plan Maestro.
Médicos de la Clínica Universitaria Bolivariana y la Universidad Pontificia Bolivariana, en asocio con científicos del Centro para el Control y la Prevención de Enfermedades- CDC - de Estados Unidos, el Museo de Historia Natural de Londres y la Universidad Asahikawa de Japón, descubren un nuevo tipo de cáncer derivado de las células de un parásito.

Construcción de un nuevo espacio deportivo, una cancha sintética reglamentaria para fútbol once. .

Conmemoración de octogésimo aniversario de la Universidad y proceso de autoevaluación multicampus con miras a la renovación de la Acreditación Intitucional.

Certificación del Centro de Conciliación en la NTC 5906 por parte de ICONTEC.

Se desarrolló y construyó el Laboratorio de Fabricación Digital en la Seccional Montería.

Desde el año 2015, la UPB realizó su autoevaluación que dio como resultado la Acreditación Institucional Multicampus por 6 años. Resolución 17228 del 24 de octubre de 2018. Inició un proceso de diversificación de la oferta, innovación curricular e incremento del relacionamiento y visibilidad. En este contexto se crea: UPB Virtual (2016), Escuela de Verano Saberes UPB (2018), UPBtec (2019), UPB Academy (2021) y UPB Open (2023).

Se inaugura el Bloque 3 en la Seccional Montería el cual cuenta con más de 5.000 M2 de construcción y 1.000M2 de urbanismo y zonas verdes.

La Universidad recibió por parte del Icontec la certificación internacional de “Carbono Neutro” Multicampus, consolidándose así como la primera universidad en Latinoamérica en obtener este reconocimiento.

El Grupo de Investigación en Dinámica Cardiovascular de la UPB recibió una distinción en la categoría “Investigación de mayor impacto en el año”, por parte de la Alcaldía de Medellín y el Centro de Ciencia y Tecnología de Antioquia, por sus avances en el bioparche que ayudaría a la conducción eléctrica del corazón.

La UPB obtuvo la categoría plata en el Sistema de Gestión Basura Cero del Icontec, con el cual demuestra sus esfuerzos por consolidar una cultura de sostenibilidad.

Este apoyará las labores de los 10 proyectos de investigación que conforman este programa, cuyo fin es brindar nuevas soluciones para la prevención, el diagnóstico y el tratamiento del cáncer de colon en el país.

La UPB conmemora el 15 de septiembre sus 85 años de fundación, tiempo en el que la Universidad se ha convertido en referente de proyección y compromiso social con Colombia. Además, rinde homenaje a los más de 100 mil egresados en toda su historia.

La Clínica Universitaria Bolivariana y la Clínica Cardio VID le realizaron una cirugía al corazón de una bebé, de 37 semanas de gestación, mientras permanecía conectada a la placenta de su madre. Este procedimiento es el primero registrado en Latinoamérica y el segundo en el mundo.

El padre Diego se desempeñaba como vicerrector pastoral de la UPB, es una persona apasionada por la sostenibilidad, el cuidado del entorno, consciente del aporte de la ciencia a los retos sociales y convencido por un humanismo fresco y cercano. Es filósofo y teólogo de la UPB. Tiene una maestría en Teología en la Pontificia Universidad Gregoriana de Roma y un doctorado en Teología de la UPB.

La UPB se destacó en el top 5, Colombia, del ´ranking´ Times Higher Education -THE-, iniciativa que destaca las instituciones que le apuestan al cumplimiento de los Objetivos de Desarrollo Sostenible. La Universidad se ubicó en el puesto número 1 en Colombia, en el cumplimiento del ODS 7: Energía Asequible y no Contaminante, gracias a proyectos como el Smart Energy Center, la instalación de paneles solares, el desarrollo de proyectos alrededor de la movilidad activa y sostenible, la investigación y proyectos de economía circular.

La Superintendencia de Industria y Comercio -SIC- concedió protección mediante la figura de patente de invención a la tecnología denominada Método de compensación de tensión en corriente directa para aprovechamiento de frenado regenerativo, desarrollada por la Universidad Pontificia Bolivariana y el Metro de Medellín.

El Consejo Directivo General de la Universidad Pontificia Bolivariana nombró al expresidente de la Corte Suprema de Justicia Jaime Alberto Arrubla Paucar como nuevo decano de la Escuela de Derecho y Ciencias Políticas. Arrubla Paucar, reconocido por su amplia trayectoria en el ámbito académico, jurídico y corporativo asumirá el liderazgo de la Escuela integrada por la tradicional Facultad de Derecho, fundadora de la Universidad, y la Facultad de Ciencias Políticas.
Somos noticias en medios de comunicación.
Hacemos presencia en diferentes lugares del país y del mundo.
UPB en Colombia y en el mundo
Los horarios de atención de la Universidad son de lunes a viernes de 7 AM a 12 M y de 2 PM a 6 PM
la Universidad Pontifica Bolivariana fue erigida en calidad de persona jurídica de Derecho Canónico el 15 de septiembre de 1936, como una fundación de la Iglesia Católica, elevada a la calidad por decreto de la Sagrada Congregación para La educación Católica.
No. La Universidad Pontificia Bolivariana respeta la libertad de cultos, acoge en ella a todo aquel que tenga interés en formarse como profesional a la luz del humanismo cristiano.
Por favor, visita la sección de preguntas frecuentes antes de escribirnos.



Universidad Pontificia Bolivariana Seccional Bucaramanga.
Autopista a Piedecuesta Kilómetro 7
(+574) 6796220 Ext 20414 - 20642 - 20300
info@upb.edu.co




Carrera 6 No. 97 A - 99
Montería, Córdoba - COLOMBIA
Recepción documentos: gdocumental.monteria@upb.edu.co
Recepción facturación: facturacion.monteria@upb.edu.co



Resolución 020198 del 31 de octubre de 2024 por un periodo de 8 años
Universidad sujeta a inspección y vigilancia por el Ministerio de Educación Nacional.
Otorgado por el Ministerio de Educación Nacional. Nit UPB: 890.902.922-6. Todos los derechos reservados